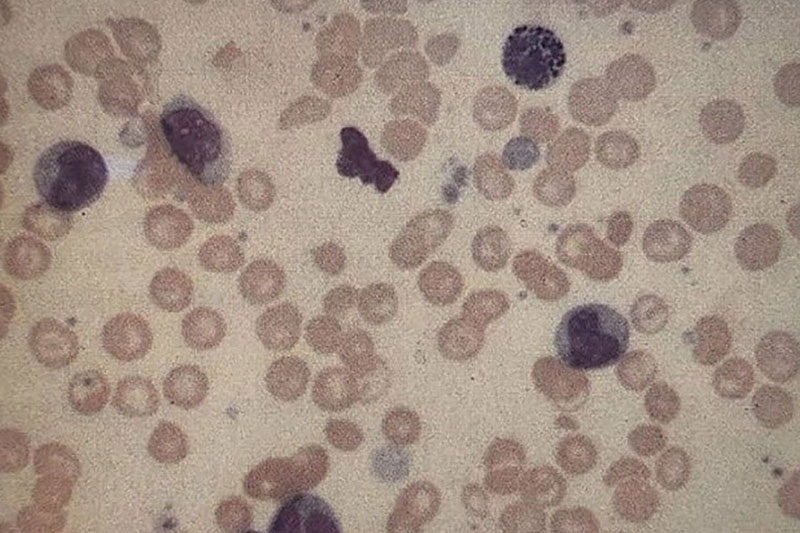

مطالعه مودری بیمار شماره 54، تشخیص شما چیست؟
شرح حال بیمار
مردی ۴۸ ساله متوجه تورمی در قسمت فوقانی چپ شکم خود شد و به همین علت به یک مرکز درمانی مراجعه کرد.
در معاینه بالینی، طحال بهراحتی قابل لمس است (splenomegaly)
هیچ سابقهای از سفر خارجی، یرقان، مصرف دارو یا بیماری مزمن کبدی وجود ندارد. بیمار تنها گاهی الکل مصرف میکند.
نتایج آزمایش شمارش کامل خون (CBC) بیمار به شرح زیر است:
Hb: 14.3 g/dl
WBC: 114 × 10⁹/L
84% :نوتروفیلها
1% :بلاستها
4% :میلوسیتها
1% :پرومیِلوسیتها
5% :متامیِلوسیتها
9% :لنفوسیتها
Platelets: 438 × 10⁹/L

سوالات
1. نظر شما در مورد گسترش خون محیطی بیمار چیست؟ (شکل 54a,54b)
اسمیر خونی (blood film) افزایش تعداد نوتروفیلها (لکوسیتوز نوتروفیلی) را همراه با حضور سلولهای گرانولوسیتی نابالغ نشان میدهد. عدم وجود سلولهای اریتروئیدی نابالغ بیانگر آن است که این یافتهها مربوط به یک اختلال میلوپرولیفراتیو هستند، نه یک اسمیر خونی لوکواریتروبلاستیک (leukoerythroblastic blood film).
2. چه آزمایشهای دیگری باید انجام شود؟
لازم است آسپیراسیون مغز استخوان انجام شود و آزمایش سیتوژنتیک درخواست گردد.
بیش از ۹۵٪ بیماران مبتلا به لوسمی میلوئیدی مزمن دارای جابهجایی ماده کروموزومی از کروموزوم ۹ به ۲۲ هستند (کروموزوم فیلادلفیا t9:22 ).
این بدان معناست که انکوژن Abelson (ABL) به ناحیه شکست خوشهای (breakpoint cluster region bcr) از کروموزوم ۲۲ منتقل میشود و در نتیجه، پروتئینی کایمریک با فعالیت تیروزین کینازی ایجاد میگردد که چندین برابر همتای طبیعی خود فعالیت دارد. آسپیراسیون و بیوپسی مغز استخوان (trephine) افزایش سلولاریته یا سلولزایی را نشان خواهد داد. همچنین، انجام سونوگرافی شکم برای تأیید اسپلنومگالی (بزرگی طحال) لازم است انجام شود.
تست های عملکرد کبد، اوره و الکترولیت ها و LDH سرم باید انجام شوند. آزمایش فسفاتاز آلکالن نوتروفیلی (تست سیتوشیمیائی بر روی نوتروفیل ها در خونی که تازه تهیه شده است) عدد کمتر از 10 رانشان می دهد (مقدار طبیعی آن 80 الی 120 است).
3. محتملترین تشخیص چیست؟
تشخیص لوسمی میلوئیدی مزمن (Chronic Granulocytic Leukaemia / CML) است.
4. بیمار باید چگونه درمان شود؟
این وضعیت دارای یک فاز مزمن نسبتاً خوشخیم است که میانگین طول آن حدود ۲٫۵ سال میباشد.
در این مدت، وضعیت عمومی بیمار خوب است و بیماری بهراحتی با شیمیدرمانی خوراکی مانند هیدروکسیاوره (Hydroxyurea) یا بوسولفان (Busulphan) کنترل میشود.
در حال حاضر، استفاده از اینترفرون نوترکیب (Recombinant Interferon) مورد توجه است؛ زیرا میتواند فاز مزمن بیماری را طولانیتر کرده و در درصد کمی از بیماران، سبب خونسازی فاقد کروموزوم فیلادلفیا (Philadelphia-negative haemopoiesis) شود.
پیوند مغز استخوان (Bone marrow transplantation) در این مرحله میتواند درمان قطعی (curative) باشد.
هنگامی که بیماری وارد فاز بلاستیک (Blast Crisis) شود، معمولاً به درمان مقاوم میگردد.
بحران بلاست ممکن است از نوع میلوئیدی یا لنفوئیدی باشد، اما گاهی سلولهای بلاست ویژگیهای دوگانه (دو ردهای) نشان میدهند.
سلولهای نشان دادهشده در تصویر54c شواهدی از هر دو نوع تمایز میلوئیدی, CD33) CD13مثبت) و تمایز لنفوئیدی (CD19،TdT مثبت) دارند.

